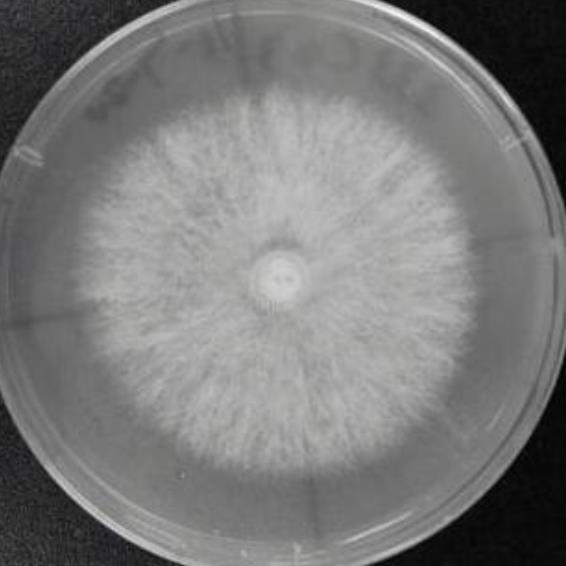
维隆气单胞菌
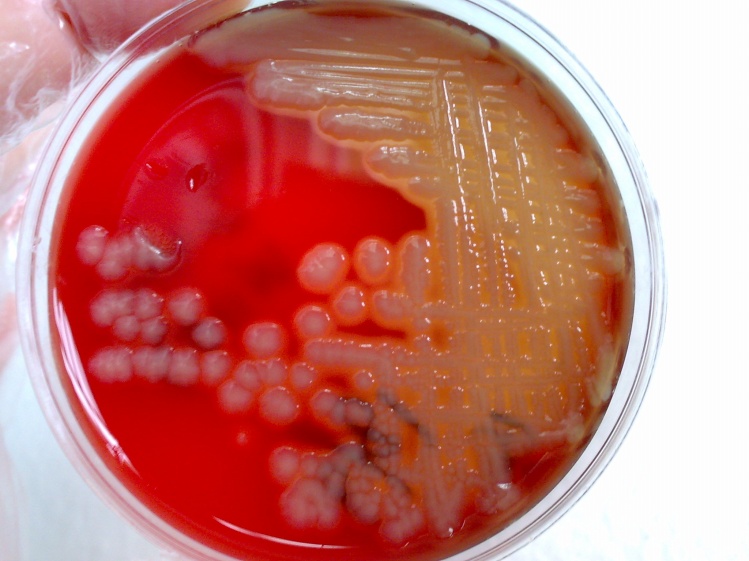
嗜水气单胞菌

气单胞菌图片

维隆气单胞菌
图片尺寸566x566
气单胞菌中检测到新的耐药基因aac(6)-ib-cr和qnrs
图片尺寸900x653
气单胞菌属
图片尺寸588x554
嗜水气单胞菌肠炎
图片尺寸500x375
嗜水气单胞菌
图片尺寸749x561
温和气单胞菌
图片尺寸1201x800
温和气单胞菌
图片尺寸381x221
嗜水气单胞菌肠炎
图片尺寸500x312
气单胞菌属
图片尺寸934x700
一种气单胞菌属菌株r1及制备方法及其在溶藻降解微囊藻毒素上的应用
图片尺寸651x624
嗜水气单胞菌对四环素类和氟喹诺酮类药物的耐药性研究
图片尺寸1280x960
维氏气单胞菌规格
图片尺寸600x600
气单胞菌引起欧鳗春季"头部溃疡"一例
图片尺寸541x282
罗氏沼虾豚鼠气单胞菌的分离鉴定
图片尺寸426x480
据医院方面表示,初步怀疑其可能是嗜水气单胞菌感染,不过最终是否确为
图片尺寸749x562
气单胞菌目 – aeromonadales 40. 纤维杆菌门
图片尺寸440x299
气单胞菌属aminomonas paucivorans
图片尺寸576x277
今天给大家展示一下嗜水气单胞菌!
图片尺寸1080x1439
病原体:假,气单胞杆菌,黏细菌,弧菌或者黄杆菌溃烂的头胸甲溃烂的头
图片尺寸463x374
气单胞菌引起欧鳗春季"头部溃疡"一例
图片尺寸550x281